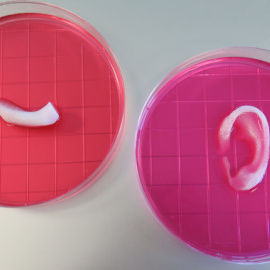
Oreja y mandíbula construidas gracias al nuevo sistema integrado de impresión de tejidos de organos. /Wake Forest Institute for Regenerative Medicine

Sinc
Todos los artículos de Sinc
-
¿Sabes cuáles suelen ser los motivos ocultos tras las acciones altruistas?
Sinc | 04 Mar 2016 - 11:21 CET

-
La libélula ‘trotamundos’, el animal que vuela las distancias más largas
Sinc | 03 Mar 2016 - 13:10 CET

-
España crece un 3,8% en solicitudes de patentes europeas
Sinc | 03 Mar 2016 - 13:02 CET

-
Detectan 66 genes relacionados con el autismo en sangre y cerebro
Sinc | 02 Mar 2016 - 19:14 CET

-
Confirman que el zika puede causar síndrome de Guillain-Barré
Sinc | 01 Mar 2016 - 10:40 CET
 Publicidad
Publicidad -
Una terapia adaptada para controlar el cáncer en lugar de erradicarlo
Sinc | 25 Feb 2016 - 10:53 CET

-
La historia de la evolución humana escrita en los dientes
Sinc | 25 Feb 2016 - 10:47 CET

-
Un microscopio 3D desvela detalles de las células cancerosas
Sinc | 23 Feb 2016 - 10:26 CET

-
El anuncio de Charlie Sheen dispara la búsqueda de datos sobre VIH
Sinc | 23 Feb 2016 - 10:16 CET

-
Perros policía identifican a los sospechosos por su olor sin errores
Sinc | 22 Feb 2016 - 11:18 CET
 Publicidad
Publicidad -
La cámara Polaroid cumple 69 años, recuperada en el universo digital
Sinc | 21 Feb 2016 - 19:00 CET

-
Sapiens y neandertales tuvieron hijos hace 100.000 años
Sinc | 18 Feb 2016 - 00:04 CET

-
Imprimen en 3D hueso, cartílago y músculo humano a tamaño real
Sinc | 16 Feb 2016 - 11:35 CET

-
Una impresora crea huesos, cartílagos y músculos humanos en 3D a tamaño real
Sinc | 15 Feb 2016 - 19:39 CET
-
El misterio sobre el superbólido de Cheliábinsk continúa 3 años después
Sinc | 15 Feb 2016 - 12:44 CET
 Publicidad
Publicidad -
Así vivieron cinco investigadores españoles el descubrimiento de las ondas gravitacionales
Agencia SINC | 13 Feb 2016 - 11:50 CET

-
La fusión de dos agujeros negros produjo la onda gravitacional descubierta por el LIGO
Sinc | 11 Feb 2016 - 17:54 CET

-
¿Te gustaría enviar un mensaje al espacio exterior?
Sinc | 11 Feb 2016 - 10:51 CET

-
Un email filtrado alimenta los rumores sobre las ondas gravitacionales
Sinc | 10 Feb 2016 - 14:12 CET

-
Rastros de animales revelan las huellas más antiguas de Catalunya
Sinc | 10 Feb 2016 - 12:28 CET
 Publicidad
Publicidad -
La herramienta Mybullying detecta el acoso escolar en solo diez minutos
Sinc | 10 Feb 2016 - 11:20 CET

-
Los tres primeros implantados con un ojo biónico muestran importantes avances en su visión
Sinc | 10 Feb 2016 - 11:02 CET

-
Cáncer rico, cáncer pobre
Sinc | 01 Feb 2016 - 13:03 CET

-
El oso panda Chu-Lin 'vivirá' en el museo de Ciencias Naturales
Adeline Marcos (SINC) | 29 Jan 2016 - 14:02 CET

-
Los antiguos babilonios ya rastreaban a Júpiter con geometría avanzada
Sinc | 29 Jan 2016 - 11:52 CET
 Publicidad
Publicidad -
Una ecuación matemática echa por tierra las teorías 'conspiranoicas' sobre la llegada del hombre a la Luna
Agencia SINC | 27 Jan 2016 - 15:48 CET

-
Hongos de la Antártida sobreviven a condiciones marcianas en la Estación Espacial Internacional
Agencia SINC | 26 Jan 2016 - 13:37 CET

-
Amores, venganzas y mensajes ocultos en los nombres de las especies
Sinc | 25 Jan 2016 - 18:19 CET

-
Masacre prehistórica: ¿Es la guerra un acto inherente al ser humano?
Sinc | 21 Jan 2016 - 10:44 CET

-
Dracoraptor hanigani, el dinosaurio del Jurásico en Gales
Agencia SINC | 21 Jan 2016 - 10:42 CET


